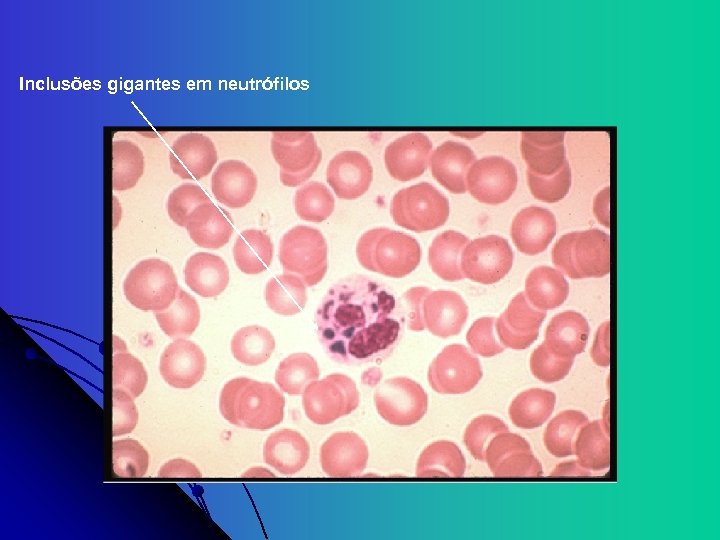
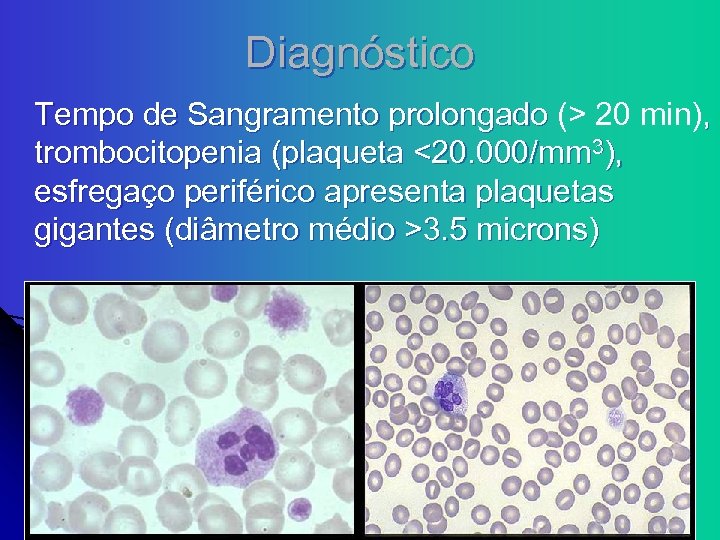

5b8db043805f2ed3e8ebc41e5419aad8.ppt
- Количество слайдов: 103
 Defeito Funcional Plaquetário Hereditário e Adquirido Reunião Clínica do CHSP Nydia S Bacal nsbacal@einstein. br hemato@chsp. org. com. br 26, Setembro, 2007
Defeito Funcional Plaquetário Hereditário e Adquirido Reunião Clínica do CHSP Nydia S Bacal nsbacal@einstein. br hemato@chsp. org. com. br 26, Setembro, 2007
 Objetivo l Morfologia plaquetária e hemostasia primária l Defeitos plaquetários hereditários e adquiridos l Métodos laboratoriais no diagnóstico e classificação das disfunções plaquetárias
Objetivo l Morfologia plaquetária e hemostasia primária l Defeitos plaquetários hereditários e adquiridos l Métodos laboratoriais no diagnóstico e classificação das disfunções plaquetárias
 Plaqueta l l Célula discóide anuclear (3 -5 microns). Fragmentos do citoplasma de megacariócitos da medula óssea. Maturação 4 -5 dias, meia vida 9 -10 dias Membrana bilaminar que contem várias invaginações com um sistema canalicular aberto: l l Ligado intracelularmente a um sistema tubular denso, formando uma rede de interconexão através da célula (complexo membránico) Facilita a secreção dos grânulos
Plaqueta l l Célula discóide anuclear (3 -5 microns). Fragmentos do citoplasma de megacariócitos da medula óssea. Maturação 4 -5 dias, meia vida 9 -10 dias Membrana bilaminar que contem várias invaginações com um sistema canalicular aberto: l l Ligado intracelularmente a um sistema tubular denso, formando uma rede de interconexão através da célula (complexo membránico) Facilita a secreção dos grânulos
 Célula não nucleada com meia-vida de 7 a 10 dias. Pode reduzir a meia-vida para 3 a 4 dias indicando aumento de consumo, aumento do turnover plaquetário. (geneticamente? patológicamente? ) A estabilidade é conseguida por dois sistemas de canais inter-conectados no interior da plaqueta: a fina rede de ligação do canal –sistema tubular denso (amarelo) e os tubos tipo saco (azul) o qual também prove a conexão com o exterior. Um espiral de microtubulos mantém a forma discóide da plaqueta. A membrana plaquetária estica como um guarda chuva em espiral e circula na corrente sanguínea. A plaqueta é altamente especializada e diferenciada. Além dos dois sistemas de canais apresenta outras organelas (mitocondrias, lisossomos, grânulos de estocagem de glicogênio, etc…).
Célula não nucleada com meia-vida de 7 a 10 dias. Pode reduzir a meia-vida para 3 a 4 dias indicando aumento de consumo, aumento do turnover plaquetário. (geneticamente? patológicamente? ) A estabilidade é conseguida por dois sistemas de canais inter-conectados no interior da plaqueta: a fina rede de ligação do canal –sistema tubular denso (amarelo) e os tubos tipo saco (azul) o qual também prove a conexão com o exterior. Um espiral de microtubulos mantém a forma discóide da plaqueta. A membrana plaquetária estica como um guarda chuva em espiral e circula na corrente sanguínea. A plaqueta é altamente especializada e diferenciada. Além dos dois sistemas de canais apresenta outras organelas (mitocondrias, lisossomos, grânulos de estocagem de glicogênio, etc…).

 Organelas da Plaqueta l Mitocondria, Aparelho de Golgi, ribossomos, peroxisomos, lisossomos l Dois tipos de Grânulos de armazenamento: l Grânulos Alpha: Fator 4 Plaquetário , PDGF, fibrinogênio, fibronectina, inibidor I do ativador de plasminogênio (PAI I), Fatores V, VIII, e Fv. W l Corpos Densos: histamina, epinefrina, serotonina, ADP, cálcio
Organelas da Plaqueta l Mitocondria, Aparelho de Golgi, ribossomos, peroxisomos, lisossomos l Dois tipos de Grânulos de armazenamento: l Grânulos Alpha: Fator 4 Plaquetário , PDGF, fibrinogênio, fibronectina, inibidor I do ativador de plasminogênio (PAI I), Fatores V, VIII, e Fv. W l Corpos Densos: histamina, epinefrina, serotonina, ADP, cálcio
 membrana microtubulos Sistema tubular denso Sistema canalicular conectado a superfície Mitocondria Grânulos de glicogênio Grânulos Densos Grânulos α
membrana microtubulos Sistema tubular denso Sistema canalicular conectado a superfície Mitocondria Grânulos de glicogênio Grânulos Densos Grânulos α
 Citoesqueleto plaquetário l l Composto de filamentos de actina cruzados, ligados a superfície interna da dupla membrana lipídica Regula a forma da plaqueta em repouso Interage com os receptores transmembranicos Ativação plaquetária através da cascata de fosforilação proteica intracelular leva a sua contração e liberação do conteúdo das organelas plaquetárias
Citoesqueleto plaquetário l l Composto de filamentos de actina cruzados, ligados a superfície interna da dupla membrana lipídica Regula a forma da plaqueta em repouso Interage com os receptores transmembranicos Ativação plaquetária através da cascata de fosforilação proteica intracelular leva a sua contração e liberação do conteúdo das organelas plaquetárias

 PLAQUETAS Sistema canicular aberto Sistema Tubular Denso Grânulo α Microtubulos Grânulo Denso Filamentos Actínicos Estoque de glicogênio Miosina Mitocondria Degranulação – liberação do conteúdo dos grânulos α e densos Mudança de forma (discóide para esférica) e extensão de pseudópodes
PLAQUETAS Sistema canicular aberto Sistema Tubular Denso Grânulo α Microtubulos Grânulo Denso Filamentos Actínicos Estoque de glicogênio Miosina Mitocondria Degranulação – liberação do conteúdo dos grânulos α e densos Mudança de forma (discóide para esférica) e extensão de pseudópodes
 Superfície plaquetária l Possui numerosos receptores G-proteicos ou receptores de adesão (integrinas): l heterodímeros transmembranicos compostos de subunidades alpha e beta, responsáveis pela adesão e sinais de transdução l São glicoproteinas designadas de I até IX (de forma decrescente conforme tamanho molecular); e de a e b conforme tipo de bandas obtidas por eletroforese
Superfície plaquetária l Possui numerosos receptores G-proteicos ou receptores de adesão (integrinas): l heterodímeros transmembranicos compostos de subunidades alpha e beta, responsáveis pela adesão e sinais de transdução l São glicoproteinas designadas de I até IX (de forma decrescente conforme tamanho molecular); e de a e b conforme tipo de bandas obtidas por eletroforese
 Glicoproteinas receptoras GP Ib-V-IX: complexo de quatro produtos gênicos, serve como um receptor para Fv. W; adesão - (Bernard-Soulier) l GP IIb-IIIa: mais abundante, reconhece os quatro receptores de adesão: fibrinogênio, fibronectina, vitronectina, e Fv. W; agregação - (Glanzmann) l Outros: l l GP Ia, IIa; GP VI: receptores do colágeno
Glicoproteinas receptoras GP Ib-V-IX: complexo de quatro produtos gênicos, serve como um receptor para Fv. W; adesão - (Bernard-Soulier) l GP IIb-IIIa: mais abundante, reconhece os quatro receptores de adesão: fibrinogênio, fibronectina, vitronectina, e Fv. W; agregação - (Glanzmann) l Outros: l l GP Ia, IIa; GP VI: receptores do colágeno
 Hemostasia Primária l Extremamente dinâmica, interação contínua entre vaso, plaqueta, e componentes do plasma l Adesão, Ativação (Secreção), Agregação
Hemostasia Primária l Extremamente dinâmica, interação contínua entre vaso, plaqueta, e componentes do plasma l Adesão, Ativação (Secreção), Agregação
 Adesão l l Rompimento vascular expõe os componentes pró-coagulantes do sub-endotélio (matrix extracelular, colágeno, proteoglicanos, e fibronectina); O Fv. W atua como uma ponte de adesão entre o complexo GP Ib-V-IX da plaqueta e o colágeno exposto; As plaquetas aderem-se a fibronectina das microfibrilas subendoteliais; A associação Fv. W-GPIb é a ligação mais forte para superar a força do fluxo sanguíneo.
Adesão l l Rompimento vascular expõe os componentes pró-coagulantes do sub-endotélio (matrix extracelular, colágeno, proteoglicanos, e fibronectina); O Fv. W atua como uma ponte de adesão entre o complexo GP Ib-V-IX da plaqueta e o colágeno exposto; As plaquetas aderem-se a fibronectina das microfibrilas subendoteliais; A associação Fv. W-GPIb é a ligação mais forte para superar a força do fluxo sanguíneo.

 Subendotélio
Subendotélio

 Secreção - Ativação l l Mudança da forma de discóide para esférica com extensão de pseudópodes promovida pela contração do citoesqueleto Conteúdo dos Granulos plaquetários são liberados através do sistema canalicular A contração do citoesqueleto ocorre pelo aumento do Ca iônico intraplaquetário, modulado pela redução do AMPc e aumento de ADP proveniente da via das prostaglandinas (TXA 2) Também são expostos fosfolipídios na superfície da membrana plaquetária, que são receptores dos fatores da coagulação vitamina K dependentes (Fator II, IX, X)
Secreção - Ativação l l Mudança da forma de discóide para esférica com extensão de pseudópodes promovida pela contração do citoesqueleto Conteúdo dos Granulos plaquetários são liberados através do sistema canalicular A contração do citoesqueleto ocorre pelo aumento do Ca iônico intraplaquetário, modulado pela redução do AMPc e aumento de ADP proveniente da via das prostaglandinas (TXA 2) Também são expostos fosfolipídios na superfície da membrana plaquetária, que são receptores dos fatores da coagulação vitamina K dependentes (Fator II, IX, X)

 Contraste de Fase
Contraste de Fase
 Via das Prostaglandinas Ciclooxigenase Prostaglandinas (AAS) Tromboxane Sintetase (Clopidogrel) Prostaciclina Sintetase ↓ Ca++ ↑ Prostaciclina (PGI 2): poderoso antiagregante plaquetário e vasodilatador Tromboxane A 2: poderoso agregante plaquetário e vasoconstrictor Drogas Antiagregantes interferem nesses mecanismos
Via das Prostaglandinas Ciclooxigenase Prostaglandinas (AAS) Tromboxane Sintetase (Clopidogrel) Prostaciclina Sintetase ↓ Ca++ ↑ Prostaciclina (PGI 2): poderoso antiagregante plaquetário e vasodilatador Tromboxane A 2: poderoso agregante plaquetário e vasoconstrictor Drogas Antiagregantes interferem nesses mecanismos
 Agregação l A contração da plaqueta provocada pela reação de liberação propicia: l Mudança conformacional dos receptores IIb. IIIa, permitindo a ligação do fibrinogênio l Agregação plaquetária via fibrinogênio l Reação auto-catalítica ativando outras plaquetas l Formação do plug primário hemostático
Agregação l A contração da plaqueta provocada pela reação de liberação propicia: l Mudança conformacional dos receptores IIb. IIIa, permitindo a ligação do fibrinogênio l Agregação plaquetária via fibrinogênio l Reação auto-catalítica ativando outras plaquetas l Formação do plug primário hemostático






 PLAQUETOPATIAS CONGÊNITAS Raras PORÉM. . . Diagnósticos errados - terapias erradas Corticóide, reposição de Fv. W , Esplenectomia, ou omissão de tratamento
PLAQUETOPATIAS CONGÊNITAS Raras PORÉM. . . Diagnósticos errados - terapias erradas Corticóide, reposição de Fv. W , Esplenectomia, ou omissão de tratamento
 Quando Suspeitar ? História Familiar - Dois ou mais parentes afetados Sintomas associados - Defeitos Ósseos , Surdez, Catarata congênita, Eczema, Imunodeficiência, Alterações Neurológicas Sem resposta a tratamento para PTI Visualizar em Sangue Periférico – Inclusões em Neutrófilos, Plaquetas Gigantes, Alteração dos grânulos Sangramento desproporcional ao Nível Plaquetário Plaquetopenia há muitos anos Sangramento desde infância
Quando Suspeitar ? História Familiar - Dois ou mais parentes afetados Sintomas associados - Defeitos Ósseos , Surdez, Catarata congênita, Eczema, Imunodeficiência, Alterações Neurológicas Sem resposta a tratamento para PTI Visualizar em Sangue Periférico – Inclusões em Neutrófilos, Plaquetas Gigantes, Alteração dos grânulos Sangramento desproporcional ao Nível Plaquetário Plaquetopenia há muitos anos Sangramento desde infância
 EXAMES LABORATORIAIS NA AVALIAÇÃO PLAQUETÁRIA Contagem Manual de Plaquetas Importante contadores automáticos não contam plaquetas com > 20 f. L analisadores automaticos hematológicos com atc monoclonais Avaliar Morfologia Plaquetária Confirmar trombocitopenia Tamanho (macroplaquetas, microplaquetas) Grânulos plaquetários Tempo de Sangramento – Ivy Agregação Plaquetária Técnica de Born PFA – 100 x TS Adesividade Plaquetária – Técnica de Salzman Impact – (Diamed) Citometria de Fluxo Proteínas de superfície plaquetária CD 41 (GPIIb) e CD 61 (GPIIIa),
EXAMES LABORATORIAIS NA AVALIAÇÃO PLAQUETÁRIA Contagem Manual de Plaquetas Importante contadores automáticos não contam plaquetas com > 20 f. L analisadores automaticos hematológicos com atc monoclonais Avaliar Morfologia Plaquetária Confirmar trombocitopenia Tamanho (macroplaquetas, microplaquetas) Grânulos plaquetários Tempo de Sangramento – Ivy Agregação Plaquetária Técnica de Born PFA – 100 x TS Adesividade Plaquetária – Técnica de Salzman Impact – (Diamed) Citometria de Fluxo Proteínas de superfície plaquetária CD 41 (GPIIb) e CD 61 (GPIIIa),
 Estudo da Agregação Plaquetária Agentes agregantes l l Concentrações diferentes de cada agente levam à formas diferentes de curvas ADP, ADN e Colágeno permitem a obtenção de curvas com duas ondas. l l Primeira onda: efeito direto do agente agregante Segunda onda: representa a reação de liberação plaquetária Ácido aracdônico Ristocetina (antibiótico): teste de aglutinação plaquetária dependente do Fv. W, pode ser realizada com plaquetas fixadas com formol l Defeito na agregação induzida com Ristocetina é característico de Bernard-Soulier
Estudo da Agregação Plaquetária Agentes agregantes l l Concentrações diferentes de cada agente levam à formas diferentes de curvas ADP, ADN e Colágeno permitem a obtenção de curvas com duas ondas. l l Primeira onda: efeito direto do agente agregante Segunda onda: representa a reação de liberação plaquetária Ácido aracdônico Ristocetina (antibiótico): teste de aglutinação plaquetária dependente do Fv. W, pode ser realizada com plaquetas fixadas com formol l Defeito na agregação induzida com Ristocetina é característico de Bernard-Soulier
 Estudo da Agregação Plaquetária PRP é preparado em sangue total citratado por leve centrifugação (cerca de 500 rpm) Agonistas ou agentes Agregantes Aumento da transmi tância da luz Registro cinético pelo Agregômetro
Estudo da Agregação Plaquetária PRP é preparado em sangue total citratado por leve centrifugação (cerca de 500 rpm) Agonistas ou agentes Agregantes Aumento da transmi tância da luz Registro cinético pelo Agregômetro

 Problemas no estudo da agregação plaquetária l Numerosas variáveis afetam a agregação: l Anticoagulante (citrato de sódio) l Plaquetometia ajustada no PRP – 150. 000 a 250. 000/mm 3 l Distribuição do tamanho plaquetário l Variação circadiana (? ) l Relação com alimentação e atividade física Atividade física diminui a concentração do AMPc – plaquetas “mais sensíveis ao ADP”, pode ser visto na hiperagregaçãodos atletas Ht alterado - corrigir o anticoagulante na coleta Tempo não pode ultrapassar 4 horas da coleta Na agregação com adrenalina aguardar 30 minutos/60 minutos
Problemas no estudo da agregação plaquetária l Numerosas variáveis afetam a agregação: l Anticoagulante (citrato de sódio) l Plaquetometia ajustada no PRP – 150. 000 a 250. 000/mm 3 l Distribuição do tamanho plaquetário l Variação circadiana (? ) l Relação com alimentação e atividade física Atividade física diminui a concentração do AMPc – plaquetas “mais sensíveis ao ADP”, pode ser visto na hiperagregaçãodos atletas Ht alterado - corrigir o anticoagulante na coleta Tempo não pode ultrapassar 4 horas da coleta Na agregação com adrenalina aguardar 30 minutos/60 minutos
 Bleeding Time - Ivy Função Vascular e Plaquetária Pressão: 40 mm. Hg Local: face anterior do antebraço Lanceta 1 cm / 1 mm de profundidade Papel de filtro a cada 30 seg. , evitando tocar as bordas do corte Duas incisões: divergência acima de 1 min devemos investigar a causa Valores normais: 7 a 9 minutos
Bleeding Time - Ivy Função Vascular e Plaquetária Pressão: 40 mm. Hg Local: face anterior do antebraço Lanceta 1 cm / 1 mm de profundidade Papel de filtro a cada 30 seg. , evitando tocar as bordas do corte Duas incisões: divergência acima de 1 min devemos investigar a causa Valores normais: 7 a 9 minutos
 PFA-100® Platelet Function Analyzer Tempo de Fechamento do Orifício (obstrução) Cartucho com 0, 8 m. L sg citratado Introdução do sg em alta velocidade através de um capilar que encontra uma membrana recoberta com colágeno / epinefrina ou colágeno / ADP que provoca adesão ativação e agregação plaquetária Obstrui um orifício de 150 µm cessa o fluxo sg. Tempo de fechamento máx: 300 seg. Afetado pelo número de plaquetas e Hematócrito, Sensível ao Fator von Willebrand Não é afetado pelo fibrinogênio, Não apresenta correlação clínica em tromboses. C. P. M. Hayward et al – PFA-100 in the evauation of platelet disorders and platelet function- J. Thromb Haemost 2006; 4: 312 -9.
PFA-100® Platelet Function Analyzer Tempo de Fechamento do Orifício (obstrução) Cartucho com 0, 8 m. L sg citratado Introdução do sg em alta velocidade através de um capilar que encontra uma membrana recoberta com colágeno / epinefrina ou colágeno / ADP que provoca adesão ativação e agregação plaquetária Obstrui um orifício de 150 µm cessa o fluxo sg. Tempo de fechamento máx: 300 seg. Afetado pelo número de plaquetas e Hematócrito, Sensível ao Fator von Willebrand Não é afetado pelo fibrinogênio, Não apresenta correlação clínica em tromboses. C. P. M. Hayward et al – PFA-100 in the evauation of platelet disorders and platelet function- J. Thromb Haemost 2006; 4: 312 -9.
 TS x PFA-100 Baixa sensibilidade na triagem de pacientes com sangramento mucocutâneo Sensibilidade: TS PFA-100 Combinação 36% (D. do Pool de Armazenamento) 30% (D. Von Willebrand) 48% Boa especificidade Especificidade: TS PFA-100 (Epinefrina) PFA-100 (ADP) 91% 84% 87% Thromb Haemost 2004: 892 Thromb Haemost 2003: 90: 483
TS x PFA-100 Baixa sensibilidade na triagem de pacientes com sangramento mucocutâneo Sensibilidade: TS PFA-100 Combinação 36% (D. do Pool de Armazenamento) 30% (D. Von Willebrand) 48% Boa especificidade Especificidade: TS PFA-100 (Epinefrina) PFA-100 (ADP) 91% 84% 87% Thromb Haemost 2004: 892 Thromb Haemost 2003: 90: 483
 Jenninngs L, White MM, Jacoski MV, Krihnat R-Journal of Thrombosis and Haemostasis, 2003
Jenninngs L, White MM, Jacoski MV, Krihnat R-Journal of Thrombosis and Haemostasis, 2003
 IMPACT (immediate microscopic platelet adhesion cone and plate technology) Dia. Med IMPACT-R Mede a função plaquetária sob pressão de atrito Sensível a função plaquetária, Fv. W, Ht e plaquetas Based upon cone and platelet viscometer developed by Varon A 130 ul of whole blood (citrated) is placed in a polystyrene plate Shear rate of 1800/s is applied for 2 min Platelets adhere and aggregate on the plate surface Washing and staining The plate is placed under a microscope connected to an image analysis system and a computer Successive images of plate are taken and the percentage of the well covered by the stained objects and the average size of these objects are quantified Kenet, G. A. et al - Br. J. Haematol. 1998. 101: 255 -259
IMPACT (immediate microscopic platelet adhesion cone and plate technology) Dia. Med IMPACT-R Mede a função plaquetária sob pressão de atrito Sensível a função plaquetária, Fv. W, Ht e plaquetas Based upon cone and platelet viscometer developed by Varon A 130 ul of whole blood (citrated) is placed in a polystyrene plate Shear rate of 1800/s is applied for 2 min Platelets adhere and aggregate on the plate surface Washing and staining The plate is placed under a microscope connected to an image analysis system and a computer Successive images of plate are taken and the percentage of the well covered by the stained objects and the average size of these objects are quantified Kenet, G. A. et al - Br. J. Haematol. 1998. 101: 255 -259
 TEG Diamandis M et al. - J Thromb Haemost. 2006 May; 4(5): 1086 -94.
TEG Diamandis M et al. - J Thromb Haemost. 2006 May; 4(5): 1086 -94.
 O anticorpo CD 42 b é diretamente ligado a glicoproteina plaquetária GPIb está ausente ou presente em baixa expressão em pacientes com Síndrome de Bernard-Soulier. A glicoproteina plaquetária GPIb atua como receptor para o Fator Von Willebrand e apresenta uma alta afinidade ao receptor de trombina. Raramente utilizamos o CD 42 a(GPIX) e o CD 42 d(GPV). Na Trombastenia de Glanzmann há diminuição ou ausência do GP IIb (CD 41) e o GP IIIa (CD 61)
O anticorpo CD 42 b é diretamente ligado a glicoproteina plaquetária GPIb está ausente ou presente em baixa expressão em pacientes com Síndrome de Bernard-Soulier. A glicoproteina plaquetária GPIb atua como receptor para o Fator Von Willebrand e apresenta uma alta afinidade ao receptor de trombina. Raramente utilizamos o CD 42 a(GPIX) e o CD 42 d(GPV). Na Trombastenia de Glanzmann há diminuição ou ausência do GP IIb (CD 41) e o GP IIIa (CD 61)
 Trombastenia de Glanzmann Eduard Glanzmann (1887 -1959), pediatra suiço Relata um caso de doença com sangramento inicial imediatamente após o nascimento W. E. Glanzmann: Hereditäre hämorrhägische Thrombasthenie. Ein Beitrag zur Pathologie der Blutplättchen. Jahrbuch für Kinderheilkunde, 1918; 88: 1 -42, 113 -141.
Trombastenia de Glanzmann Eduard Glanzmann (1887 -1959), pediatra suiço Relata um caso de doença com sangramento inicial imediatamente após o nascimento W. E. Glanzmann: Hereditäre hämorrhägische Thrombasthenie. Ein Beitrag zur Pathologie der Blutplättchen. Jahrbuch für Kinderheilkunde, 1918; 88: 1 -42, 113 -141.
 Trombastenia de Glanzmann – Quadro Clínico Menorragia Equimoses Epistaxe Gengivorragia Hemorragia TGI Hematúria Hemartrose SNC Hematoma Visceral 98% 86% 73% 55% 12% 6% 3% 2% 1% George JN et al. , Glanzmann’s thrombastenia: The spectrum of clinical disease. Blood. 1990, 75: 1383
Trombastenia de Glanzmann – Quadro Clínico Menorragia Equimoses Epistaxe Gengivorragia Hemorragia TGI Hematúria Hemartrose SNC Hematoma Visceral 98% 86% 73% 55% 12% 6% 3% 2% 1% George JN et al. , Glanzmann’s thrombastenia: The spectrum of clinical disease. Blood. 1990, 75: 1383
 Diagnóstico- Trombastenia de Glanzmann Plaquetometria e morfologia são normais l Tempo de Sangramento prolongado l Redução ou ausência da agregação plaquetária em resposta a múltiplos agonistas: ADP, AND, trombina, ou colágeno (exceção Ristocetina) l Citometria de Fluxo: diminuição da expressão do Atc Mono CD 41 (GPIIb) e CD 61 (GPIIIa) l
Diagnóstico- Trombastenia de Glanzmann Plaquetometria e morfologia são normais l Tempo de Sangramento prolongado l Redução ou ausência da agregação plaquetária em resposta a múltiplos agonistas: ADP, AND, trombina, ou colágeno (exceção Ristocetina) l Citometria de Fluxo: diminuição da expressão do Atc Mono CD 41 (GPIIb) e CD 61 (GPIIIa) l
 Trombastenia – Doença de Glanzmann - Naegeli l l Receptor da superfície plaquetária mais abundante IIb. IIIa (80, 000 por plaqueta) Complexo IIb. IIIa é um heterodímero dependente do Ca++ Genes para ambas subunidades são encontrados no Cromossomo 17 Doença Autossômica Recessiva causada por mutações (substituição, inserção, deleção) em genes codificados para IIb ou IIIa, resultando em anormalidades qualitativas ou quantitativas das proteinas
Trombastenia – Doença de Glanzmann - Naegeli l l Receptor da superfície plaquetária mais abundante IIb. IIIa (80, 000 por plaqueta) Complexo IIb. IIIa é um heterodímero dependente do Ca++ Genes para ambas subunidades são encontrados no Cromossomo 17 Doença Autossômica Recessiva causada por mutações (substituição, inserção, deleção) em genes codificados para IIb ou IIIa, resultando em anormalidades qualitativas ou quantitativas das proteinas

 O defeito fundamental do paciente com trombastenia é a inabilidade da plaqueta em se agregar l Outro problema: a plaqueta não se adere normalmente na matrix do subendotélio (devido a perda da interação da fibronectina/Fv. W e IIb. IIIa ) l Também, o fibrinogênio dos grânulos alpha está diminuído ou ausente l
O defeito fundamental do paciente com trombastenia é a inabilidade da plaqueta em se agregar l Outro problema: a plaqueta não se adere normalmente na matrix do subendotélio (devido a perda da interação da fibronectina/Fv. W e IIb. IIIa ) l Também, o fibrinogênio dos grânulos alpha está diminuído ou ausente l
 l Pacientes com Glanzmann são classificados em três grupos baseados na expressão do complexo: Tipo I menos de 5% GPIIb. IIIa, ausência de fibrinogênio no grânulo alpha Frequentemen resultado da mutação do gene IIb Tipo II <20%, fibrinogênio presente Tipo III >50%, trombastenia “variante”, doença qualitativa
l Pacientes com Glanzmann são classificados em três grupos baseados na expressão do complexo: Tipo I menos de 5% GPIIb. IIIa, ausência de fibrinogênio no grânulo alpha Frequentemen resultado da mutação do gene IIb Tipo II <20%, fibrinogênio presente Tipo III >50%, trombastenia “variante”, doença qualitativa
 Síndrome de Bernard-Soulier l Primeiro descrito em 1948 por Jean Bernard and Jean-Pierre Soulier; França Bernard J, Soulier JP: Sur une nouvelle variete de dystrophie thrombocytaire hemarroagipare congenitale. Sem Hop Paris 24: 3217, 1948 Autossômica Recessiva; caracterizada por trombocitopenia moderada a severa , plaquetas gigantes, e sangramento espontâneo l Caracterizada pela deficiência ou disfunção do complexo GP Ib-V-IX que perdem a capacidade de aderir ao Fv. W l
Síndrome de Bernard-Soulier l Primeiro descrito em 1948 por Jean Bernard and Jean-Pierre Soulier; França Bernard J, Soulier JP: Sur une nouvelle variete de dystrophie thrombocytaire hemarroagipare congenitale. Sem Hop Paris 24: 3217, 1948 Autossômica Recessiva; caracterizada por trombocitopenia moderada a severa , plaquetas gigantes, e sangramento espontâneo l Caracterizada pela deficiência ou disfunção do complexo GP Ib-V-IX que perdem a capacidade de aderir ao Fv. W l
 Síndrome Bernard-Soulier l l l A plaqueta contem cerca de 20. 000 copias do GP Ib-V-IX GP 1 b é um heterodímero com uma subunidade alpha e uma subunidade beta O gene para GP Ib alpha está localizado no cromossomo 17; GP Ib beta: cromossomo 22; GPIX e V: cromossomo 3 Muitas mutações são incompletas ou parciais resultando em parada precoce da codificação Muitas mutações envolvem a expressão do GP Ib, raramente a mutação do GP IX e não foi descrita nenhuma mutação no GP V
Síndrome Bernard-Soulier l l l A plaqueta contem cerca de 20. 000 copias do GP Ib-V-IX GP 1 b é um heterodímero com uma subunidade alpha e uma subunidade beta O gene para GP Ib alpha está localizado no cromossomo 17; GP Ib beta: cromossomo 22; GPIX e V: cromossomo 3 Muitas mutações são incompletas ou parciais resultando em parada precoce da codificação Muitas mutações envolvem a expressão do GP Ib, raramente a mutação do GP IX e não foi descrita nenhuma mutação no GP V
 Síndrome de Bernard Soulier – Quadro Clínico Epistaxe Equimoses Menorragia Gengivorragia Hemorragia TGI Pós-Trauma Hematúria SNC Sangramento Retina 70% 58% 44% 42% 22% 13% 7% 4% 2% Coller BS et al. , Hereditary Qualitative Platelet Disorders. In: Williams Hematology, 2005, 7 th Edition, Mc. Graw-Hill, p 1795 -1831
Síndrome de Bernard Soulier – Quadro Clínico Epistaxe Equimoses Menorragia Gengivorragia Hemorragia TGI Pós-Trauma Hematúria SNC Sangramento Retina 70% 58% 44% 42% 22% 13% 7% 4% 2% Coller BS et al. , Hereditary Qualitative Platelet Disorders. In: Williams Hematology, 2005, 7 th Edition, Mc. Graw-Hill, p 1795 -1831
 Diagnóstico- S. Bernard Soulier T. S. prolongado (> 20 min), Trombocitopenia (plaqueta <20. 000/mm 3), Plaquetas gigantes (diâmetro médio >3. 5 microns)
Diagnóstico- S. Bernard Soulier T. S. prolongado (> 20 min), Trombocitopenia (plaqueta <20. 000/mm 3), Plaquetas gigantes (diâmetro médio >3. 5 microns)
 Diagnóstico – S. Bernard Soulier Agregação plaquetária normal com todos os agonistas, exceção com a Ristocetina (oposto da Trombastenia) l Citometria de Fluxo: diminuição da expressão antigênica para a l GPIb – CD 42 b l GPIX – CD 42 a l GPV – CD 42 d l
Diagnóstico – S. Bernard Soulier Agregação plaquetária normal com todos os agonistas, exceção com a Ristocetina (oposto da Trombastenia) l Citometria de Fluxo: diminuição da expressão antigênica para a l GPIb – CD 42 b l GPIX – CD 42 a l GPV – CD 42 d l
 Síndrome de Bernard Soulier – Sindromes Correlatas Macrotrombocitopenia do Mediterrâneo Pacientes da região do mediterrâneo com disfunção hemorrágica, macrotrombocitopenia Heterozigose para variante de Bolzano da Síndrome de Bernard-Soulier Síndrome de Di. George Síndrome genética em que há deleção do locus 22 q 11 CATCH 22 anormalidades faciais, cardíacas, defeitos de células T, hipoparatireodismo Deleção gene da Gp Ib – no locus 22 q 11. 2 Muitos pacientes tem macrotrombocitopenia Sem diátese hemorrágica na maioria dos casos Doença de Von Willebrand Tipo Plaquetário Mutação na Gp Iba no sítio de ligação com o Fv. W Leva à ganho de função da Gp Iba consumo de plaquetas e Fv. W Macrotrombocitopenia e fenótipo semelhante à Fv. W tipo 2 b Diagnóstico diferencial utilizando agregação com plaquetas do paciente ressuspensas em plasma normal.
Síndrome de Bernard Soulier – Sindromes Correlatas Macrotrombocitopenia do Mediterrâneo Pacientes da região do mediterrâneo com disfunção hemorrágica, macrotrombocitopenia Heterozigose para variante de Bolzano da Síndrome de Bernard-Soulier Síndrome de Di. George Síndrome genética em que há deleção do locus 22 q 11 CATCH 22 anormalidades faciais, cardíacas, defeitos de células T, hipoparatireodismo Deleção gene da Gp Ib – no locus 22 q 11. 2 Muitos pacientes tem macrotrombocitopenia Sem diátese hemorrágica na maioria dos casos Doença de Von Willebrand Tipo Plaquetário Mutação na Gp Iba no sítio de ligação com o Fv. W Leva à ganho de função da Gp Iba consumo de plaquetas e Fv. W Macrotrombocitopenia e fenótipo semelhante à Fv. W tipo 2 b Diagnóstico diferencial utilizando agregação com plaquetas do paciente ressuspensas em plasma normal.
 Síndrome do Gene MYH 9 Grupo de doenças de herança autossômica dominante que tem mutação do gene MYH 9: - Anomalia de May-Hegglin (AMH) - Síndrome de Sebastian (SBS) - Síndrome de Epstein (EPTS) - Síndrome de Fechtner (FTNS) Tríade: Plaquetopenia, Plaquetas Gigantes e Inclusão em Neutrófilos tipo corpúsculo de Döhle. Características sindrômicas associadas: surdez, catarata, glomerulopatia renal. Distúrbios hemorrágico de leve intensidade ou ausente.
Síndrome do Gene MYH 9 Grupo de doenças de herança autossômica dominante que tem mutação do gene MYH 9: - Anomalia de May-Hegglin (AMH) - Síndrome de Sebastian (SBS) - Síndrome de Epstein (EPTS) - Síndrome de Fechtner (FTNS) Tríade: Plaquetopenia, Plaquetas Gigantes e Inclusão em Neutrófilos tipo corpúsculo de Döhle. Características sindrômicas associadas: surdez, catarata, glomerulopatia renal. Distúrbios hemorrágico de leve intensidade ou ausente.
 Doenças do Gene MYH 9 localiza-se no cromossomo 22 q 11 Codifica proteína da cadeia pesada da miosina não muscular IIA (NMMHC-IIA) presente em leucócitos e plaquetas Papel na função do citoesqueleto fagocitose e formação plaquetária Descritas 20 diferentes mutações em 65 famílias
Doenças do Gene MYH 9 localiza-se no cromossomo 22 q 11 Codifica proteína da cadeia pesada da miosina não muscular IIA (NMMHC-IIA) presente em leucócitos e plaquetas Papel na função do citoesqueleto fagocitose e formação plaquetária Descritas 20 diferentes mutações em 65 famílias
 Doenças do Gene MYH 9 - Quadro Laboratorial Plaquetopenia 20. 000 – 120. 000/mm 3 Presença de macrotrombócitos - maiores plaquetas descritas, cerca de 1/3 tem entre 30 -80 f. L Histograma de Plaquetas Normais Plaquetas MYH 9 Mecanismo envolvido – trombopoese ineficaz Disfunção plaquetária incapacidade de alterar sua forma por disfunção grave do citoesqueleto.
Doenças do Gene MYH 9 - Quadro Laboratorial Plaquetopenia 20. 000 – 120. 000/mm 3 Presença de macrotrombócitos - maiores plaquetas descritas, cerca de 1/3 tem entre 30 -80 f. L Histograma de Plaquetas Normais Plaquetas MYH 9 Mecanismo envolvido – trombopoese ineficaz Disfunção plaquetária incapacidade de alterar sua forma por disfunção grave do citoesqueleto.
 Doenças do Gene MYH 9 Plaqueta Gigante e Corpúsculo tipo – Döhle
Doenças do Gene MYH 9 Plaqueta Gigante e Corpúsculo tipo – Döhle
 Doenças do Gene MYH 9 Corpúsculos tipo Döhle e IHQ para NMMHC-IIA
Doenças do Gene MYH 9 Corpúsculos tipo Döhle e IHQ para NMMHC-IIA
 Doença do Pool de Armazenamento Classificada pelo tipo de deficiência: Agregação plaquetária semelhante à AAS Deficiência de corpos densos, l Deficiência de grânulos alpha: Síndrome da Plaqueta Cinzenta, l Deficiências mistas l l GP V – Plaquetopatia de Quebec
Doença do Pool de Armazenamento Classificada pelo tipo de deficiência: Agregação plaquetária semelhante à AAS Deficiência de corpos densos, l Deficiência de grânulos alpha: Síndrome da Plaqueta Cinzenta, l Deficiências mistas l l GP V – Plaquetopatia de Quebec
 Deficiência de Corpos Densos l Corpos densos estão diminuídos (ADP, ATP, Cálcio, pirofosfato, 5 HT) l Contem 3 -6 corpos densos de 300 micron
Deficiência de Corpos Densos l Corpos densos estão diminuídos (ADP, ATP, Cálcio, pirofosfato, 5 HT) l Contem 3 -6 corpos densos de 300 micron
 l Doenças hereditárias: Síndrome de Hermansky-Pudlak Síndrome Wiskott-Aldrich Síndrome de Chediak-Higashi Síndrome da ausência de rádio e trombocitopenia (TAR)
l Doenças hereditárias: Síndrome de Hermansky-Pudlak Síndrome Wiskott-Aldrich Síndrome de Chediak-Higashi Síndrome da ausência de rádio e trombocitopenia (TAR)
 Wiskott-Aldrich l l l Ligada X, defeito genético da proteina responsável pela actina na formação do citoesqueleto, proveniente de células hematopoéticas Caracterizada por trombocitopenia com defeito no pool de armazenamento plaquetário, eczema, e infecções recorrentes Sobrevida mediana 10 -20 anos. Fenômenos auto-imunes - doença inflamatória intestinal, artrite. Doenças linfoproliferativas Tratamento - Transplante de Medula óssea - Corticoesteróides
Wiskott-Aldrich l l l Ligada X, defeito genético da proteina responsável pela actina na formação do citoesqueleto, proveniente de células hematopoéticas Caracterizada por trombocitopenia com defeito no pool de armazenamento plaquetário, eczema, e infecções recorrentes Sobrevida mediana 10 -20 anos. Fenômenos auto-imunes - doença inflamatória intestinal, artrite. Doenças linfoproliferativas Tratamento - Transplante de Medula óssea - Corticoesteróides

 Hermansky-Pudlak l l l Descrita em 1959 por Hermansky e Pudlak Autossômica Recessiva, albinismo oculocutâneo, depósito tipo ceróide em lisossomos do SRE e medula óssea Associada com Fibrose pulmonar e infecções recorrentes Deficiência quantitativa dos grânulos densos com diátese hemorrágica leve a moderada Alta prevalência em Porto Rico
Hermansky-Pudlak l l l Descrita em 1959 por Hermansky e Pudlak Autossômica Recessiva, albinismo oculocutâneo, depósito tipo ceróide em lisossomos do SRE e medula óssea Associada com Fibrose pulmonar e infecções recorrentes Deficiência quantitativa dos grânulos densos com diátese hemorrágica leve a moderada Alta prevalência em Porto Rico

 Depósito tipo ceróide
Depósito tipo ceróide
 Chediak-Higashi l l l Descrito por Beguez Cesar em 1943, Steinbrinck em 1948, Chédiak em 1952, e Higashi em 1954 Autossômica Recessiva; formação microtubular anormal e grânulos lisossomais gigantes presentes em fagócitos e melanócitos Ausência de degranulação / quimiotaxia = infecções bacterianas recorrentes Albinismo oculocutâneo parcial Diminuição ou ausência de grânulos nos corpos densos
Chediak-Higashi l l l Descrito por Beguez Cesar em 1943, Steinbrinck em 1948, Chédiak em 1952, e Higashi em 1954 Autossômica Recessiva; formação microtubular anormal e grânulos lisossomais gigantes presentes em fagócitos e melanócitos Ausência de degranulação / quimiotaxia = infecções bacterianas recorrentes Albinismo oculocutâneo parcial Diminuição ou ausência de grânulos nos corpos densos
Inclusões gigantes em neutrófilos
Inclusões gigantes em neutrófilos
 Trombocitopênia com ausência de Rádio (TAR) Descrita em 1951 l Autossômica Recessiva, caracterizada por ausência de radio, trombocitopenia (com defeito no pool de armazenamento), e outras anormalidades no esqueleto, no sistema GI, sistema cardiovascular l Hemorragia é a maior causa de mortalidade l Prognóstico melhor se sobreviver por 2 anos l Etiologia não esclarecida l
Trombocitopênia com ausência de Rádio (TAR) Descrita em 1951 l Autossômica Recessiva, caracterizada por ausência de radio, trombocitopenia (com defeito no pool de armazenamento), e outras anormalidades no esqueleto, no sistema GI, sistema cardiovascular l Hemorragia é a maior causa de mortalidade l Prognóstico melhor se sobreviver por 2 anos l Etiologia não esclarecida l

 Trombocitopenia com Ausência de Rádio Greenhalg et al. Thrombocytopenia-absent radius syndrome: a clinical genetic study, J Med Genet 2002; 39: 876– 881
Trombocitopenia com Ausência de Rádio Greenhalg et al. Thrombocytopenia-absent radius syndrome: a clinical genetic study, J Med Genet 2002; 39: 876– 881
 Trombocitopenia com Sinostose Radio-Ulnar Mutação no gene HOXA 11 – hematopoiese e morfogênese Thompson AA et al. , Congenital thrombocytopenia and radio-ulnar synostosis: a new familial syndrome. Br J Haematol. 2001 Jun; 113(4): 866 -70
Trombocitopenia com Sinostose Radio-Ulnar Mutação no gene HOXA 11 – hematopoiese e morfogênese Thompson AA et al. , Congenital thrombocytopenia and radio-ulnar synostosis: a new familial syndrome. Br J Haematol. 2001 Jun; 113(4): 866 -70
 Diagnóstico Estudo da agregação plaquetária está diminuida com baixa concentração de colágeno l ADP e epinefrina mostram diminuição na resposta da segunda onda l Agregação normal com Ristocetina l Microscopia Eletrônica: perda de corpos densos l
Diagnóstico Estudo da agregação plaquetária está diminuida com baixa concentração de colágeno l ADP e epinefrina mostram diminuição na resposta da segunda onda l Agregação normal com Ristocetina l Microscopia Eletrônica: perda de corpos densos l
 Síndrome da Plaqueta Cinzenta Deficiência de Granulos Alpha Descrita por Raccuglia em 1971 l Caracterizada pela redução dos grânulos alpha nas plaquetas. (plaquetas normais contem em média 50 grânulos alpha). l Apresentam sangramento cutâneo mucoso leve a moderado l
Síndrome da Plaqueta Cinzenta Deficiência de Granulos Alpha Descrita por Raccuglia em 1971 l Caracterizada pela redução dos grânulos alpha nas plaquetas. (plaquetas normais contem em média 50 grânulos alpha). l Apresentam sangramento cutâneo mucoso leve a moderado l
 Diagnóstico Tempo de Sangramento prolongado, trombocitopenia moderada l Plaquetas grandes, acinzentadas e agranulares (ausência de cromômero) l Estudo da Agregação: diminuição ou ausência de resposta ao colágeno l
Diagnóstico Tempo de Sangramento prolongado, trombocitopenia moderada l Plaquetas grandes, acinzentadas e agranulares (ausência de cromômero) l Estudo da Agregação: diminuição ou ausência de resposta ao colágeno l
 PLAQUETOPATIAS ADQUIRIDAS l l Drogas Uremia Cirrose Mieloma Múltiplo Paraproteina interfere na interação plaquetária l Doença Mieloproliferativa(P. V. e T. E. ) Grandes multímeros Fv. W adsorvem na plaqueta l l Bypass Cardiopulmonar Plaquetas em Banco de Sangue Dispende GP Ibα, produz ácido lático, ↓p. H, hiporeatividade plaquetária, ↑ ATP, ativação com liberação do conteúdo granular, ↑ formação de trombina
PLAQUETOPATIAS ADQUIRIDAS l l Drogas Uremia Cirrose Mieloma Múltiplo Paraproteina interfere na interação plaquetária l Doença Mieloproliferativa(P. V. e T. E. ) Grandes multímeros Fv. W adsorvem na plaqueta l l Bypass Cardiopulmonar Plaquetas em Banco de Sangue Dispende GP Ibα, produz ácido lático, ↓p. H, hiporeatividade plaquetária, ↑ ATP, ativação com liberação do conteúdo granular, ↑ formação de trombina
 DIAGNÓSTICO Sem história em parentes de primeiro grau dois locais/ um local com necessidade transfusional/ um local três vezes Exame de esfregaço sanguíneo TS / Teste com PFA Descartar Doença de Von Willebrand Agregação plaquetária Citometria de Fluxo Microscopia eletrônica para plaqueta ISTH SSC Subcommittee on VWD. J Thromb Haemost 2005: 3: 775 -777
DIAGNÓSTICO Sem história em parentes de primeiro grau dois locais/ um local com necessidade transfusional/ um local três vezes Exame de esfregaço sanguíneo TS / Teste com PFA Descartar Doença de Von Willebrand Agregação plaquetária Citometria de Fluxo Microscopia eletrônica para plaqueta ISTH SSC Subcommittee on VWD. J Thromb Haemost 2005: 3: 775 -777
 1450 agregações plaquetárias realizadas Trabalho apresentado na SBPC - 2006
1450 agregações plaquetárias realizadas Trabalho apresentado na SBPC - 2006
 Estudos Farmacogênicos ISLH Miami - 2007 – Aula Dra K. Kottke-Marchant
Estudos Farmacogênicos ISLH Miami - 2007 – Aula Dra K. Kottke-Marchant
 Bases Moleculares de Resistência a Agentes Anti- Plaquetários Aspirina e Clopidogrel Usadas na prevenção de complicações ateroscleróticas Efeito terapêutico é heterogêneo Alguns pacientes não mostram inibição plaquetária esperada ou benefício com a terapia Variação: 5 a 60% Bases genômica ou proteômica não definida
Bases Moleculares de Resistência a Agentes Anti- Plaquetários Aspirina e Clopidogrel Usadas na prevenção de complicações ateroscleróticas Efeito terapêutico é heterogêneo Alguns pacientes não mostram inibição plaquetária esperada ou benefício com a terapia Variação: 5 a 60% Bases genômica ou proteômica não definida
 Fontes l Glassy, Eric ed. Color Atlas of Hematology: An Illustrated Field Guide Based on Proficiency Testing. (Northfield, Illinois: College of American Pathologists, 1998) l Ramasamy I. Inherited bleeding disorders: disorders of platelet adhesion and aggregation. Crit Rev Oncol Hematol. 2004 Jan; 49(1): 1 -35. Review. l Janeway CM, Rivard GE, Tracy PB, Mann KG. Factor V Quebec revisited. Blood. 1996 May 1; 87(9): 3571 -8. l Robbins. Pathologic Basis of Disease. 7 th ed (2004) l Hoffman, et al. Hematology: Basic Principles and Practice, 3 r ed (2000) l Aula Dra Kandice Kottke Marchant – ISLH Miami 2007 www. islh. org l Wintrobe’s - Clinical Hematology 10 th ed. Lea &Febiger
Fontes l Glassy, Eric ed. Color Atlas of Hematology: An Illustrated Field Guide Based on Proficiency Testing. (Northfield, Illinois: College of American Pathologists, 1998) l Ramasamy I. Inherited bleeding disorders: disorders of platelet adhesion and aggregation. Crit Rev Oncol Hematol. 2004 Jan; 49(1): 1 -35. Review. l Janeway CM, Rivard GE, Tracy PB, Mann KG. Factor V Quebec revisited. Blood. 1996 May 1; 87(9): 3571 -8. l Robbins. Pathologic Basis of Disease. 7 th ed (2004) l Hoffman, et al. Hematology: Basic Principles and Practice, 3 r ed (2000) l Aula Dra Kandice Kottke Marchant – ISLH Miami 2007 www. islh. org l Wintrobe’s - Clinical Hematology 10 th ed. Lea &Febiger
 l l l http: //precisionhaemostatics. com/images/mph_15. jpg http: //www. whonamedit. com/synd. cfm/2075. html http: //www. whonamedit. com/synd. cfm/1289. html www. bloodmed. com/home/hann 2 pdf/bjh_3812. pdf http: //hsc. unm. edu/pathology/medlab/pappenb. jpg http: //www. med. uth. tmc. edu/edprog/pbl/exhibits 1/images /Mason_fig_1 b. jpg www. labmed. hallym. ac. kr/ hematol/Disease-findings. htm http: //pharmacology. tmu. edu. tw/platelet. jpg www. cap. org/. . . /platelet_ disorders_feature. faculty. washington. edu/ kepeter/118/photos/blo. . . http: //web. mit. edu/cherish/www/new%20 images/platelet. j pg www. macmed. ttuhsc. edu/. . . / pages/newpage 20. htm
l l l http: //precisionhaemostatics. com/images/mph_15. jpg http: //www. whonamedit. com/synd. cfm/2075. html http: //www. whonamedit. com/synd. cfm/1289. html www. bloodmed. com/home/hann 2 pdf/bjh_3812. pdf http: //hsc. unm. edu/pathology/medlab/pappenb. jpg http: //www. med. uth. tmc. edu/edprog/pbl/exhibits 1/images /Mason_fig_1 b. jpg www. labmed. hallym. ac. kr/ hematol/Disease-findings. htm http: //pharmacology. tmu. edu. tw/platelet. jpg www. cap. org/. . . /platelet_ disorders_feature. faculty. washington. edu/ kepeter/118/photos/blo. . . http: //web. mit. edu/cherish/www/new%20 images/platelet. j pg www. macmed. ttuhsc. edu/. . . / pages/newpage 20. htm
 Obrigada pela Atenção ! Nydia Strachman Bacal nsbacal@einstein. br hemato@chsp. org. br
Obrigada pela Atenção ! Nydia Strachman Bacal nsbacal@einstein. br hemato@chsp. org. br
 Drogas
Drogas
 ISLH Miami - 2007 – Aula Dra K. Kottke-Marchant
ISLH Miami - 2007 – Aula Dra K. Kottke-Marchant





 Outros agonistas l Epinefrina: trifásica (plaqueta em repouso, agregação primária, agregação secundária)
Outros agonistas l Epinefrina: trifásica (plaqueta em repouso, agregação primária, agregação secundária)


 Síndrome de Bernard Soulier - Fisiopatologia Sítio de Ligação Defeito na com o Fv. W e a adesão das Trombina ao plaquetas na Gp. Iba Fv. W Formação de Adesão com macroplaquetas e citoesqueleto e trombocitopenia proteínas sinalizadoras
Síndrome de Bernard Soulier - Fisiopatologia Sítio de Ligação Defeito na com o Fv. W e a adesão das Trombina ao plaquetas na Gp. Iba Fv. W Formação de Adesão com macroplaquetas e citoesqueleto e trombocitopenia proteínas sinalizadoras
 Como a plaqueta promove a hemostasia
Como a plaqueta promove a hemostasia
Diagnóstico Tempo de Sangramento prolongado (> 20 min), trombocitopenia (plaqueta <20. 000/mm 3), esfregaço periférico apresenta plaquetas gigantes (diâmetro médio >3. 5 microns)
Diagnóstico Tempo de Sangramento prolongado (> 20 min), trombocitopenia (plaqueta <20. 000/mm 3), esfregaço periférico apresenta plaquetas gigantes (diâmetro médio >3. 5 microns)
 Diagnóstico Agregação plaquetária normal com todos os agonistas, exceção com a Ristocetina (oposto da Trombastenia) l Citometria de Fluxo: diminuição da expressão antigênica para a l GPIb – CD 42 b l GPIX – CD 42 a l GPV – CD 42 d l
Diagnóstico Agregação plaquetária normal com todos os agonistas, exceção com a Ristocetina (oposto da Trombastenia) l Citometria de Fluxo: diminuição da expressão antigênica para a l GPIb – CD 42 b l GPIX – CD 42 a l GPV – CD 42 d l
 O anticorpo CD 42 b é diretamente ligado a glicoproteina plaquetária GPIb Essa glicoproteina plaquetária atua como receptor para o Fator Von Willebrand e apresenta uma alta afinidade ao receptor de trombina. Raramente utilizamos o CD 42 a(GPIX) e o CD 42 d(GPV). O antígeno está ausente ou presente em baixa expressão em pacientes com Síndrome de Bernard-Soulier. CD 41 (GPIIb) and CD 61 (GPIIIa) – Trombastenia de Glanzmann
O anticorpo CD 42 b é diretamente ligado a glicoproteina plaquetária GPIb Essa glicoproteina plaquetária atua como receptor para o Fator Von Willebrand e apresenta uma alta afinidade ao receptor de trombina. Raramente utilizamos o CD 42 a(GPIX) e o CD 42 d(GPV). O antígeno está ausente ou presente em baixa expressão em pacientes com Síndrome de Bernard-Soulier. CD 41 (GPIIb) and CD 61 (GPIIIa) – Trombastenia de Glanzmann
 Bleeding Time - Ivy PFA-100® Platelet Function Analyzer
Bleeding Time - Ivy PFA-100® Platelet Function Analyzer
 TS x PFA-100 • Baixa sensibilidade para triagem de pacientes com sangrameno mucocutâneo Sensibilidade: TS PFA-100 Combinação 36% (D. do Pool de Armazenamento) 30% (D. Von Willebrand) 48% • Boa especificidade Especificidade: TS PFA-100 (Epinefrina) PFA-100 (ADP) 91% 84% 87% Thromb Haemost 2004: 892 Thromb Haemost 2003: 90: 483
TS x PFA-100 • Baixa sensibilidade para triagem de pacientes com sangrameno mucocutâneo Sensibilidade: TS PFA-100 Combinação 36% (D. do Pool de Armazenamento) 30% (D. Von Willebrand) 48% • Boa especificidade Especificidade: TS PFA-100 (Epinefrina) PFA-100 (ADP) 91% 84% 87% Thromb Haemost 2004: 892 Thromb Haemost 2003: 90: 483


